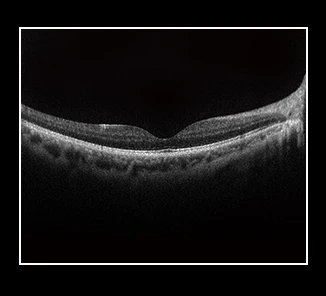
Latest  Optical Coherence Tomography Scanner Eye Examination Ophthalmic Optical Equipments fundus camera

Latest Optical Coherence Tomography Scanner Eye Examination Ophthalmic Optical Equipments fundus camera
- Category: >>>
- Supplier: ZD Medical Inc.
Share on (62590174306):
Product Overview
Description
| Product Name | Ophthalmic Optical Equipments |
| MOQ | 1 PC |
| Certificate | CE ISO |
| Warranty: | 1 Year |
| Language | English |
| Color | white |
| Function | rapid screening of fundus diseases |
| Instrument classification | Class II |
| Customized | Acceptable |
| Aplication | Eye examination,Fundus disease screening,Hospital |
| Port | Shanghai/Shenzhen |








Q1: Wonder if you accept small orders?
A1: Do not worry. Feel free to contact us .in order to get more orders and give our clients more convener ,we accept small order.
Q2: Can you send products to my country?
A2: Sure, we can. If you do not have your own ship forwarder, we can help you.
Q3: Can you do OEM for me?
A3: We accept all OEM orders,just contact us and give me your design.we will offer you a reasonable price and make samples for you ASAP.
Q4: What's your payment terms ?
A4: By T/T,LC AT SIGHT,30% deposit in advance, balance 70% before shipment.
Q5: How can I place the order?
A5: First sign the PI,pay deposit,then we will arrange the production.After finished production need you pay balance. Finally we will ship the Goods.
Q7: When can I get the quotation ?
A7: We usually quote you within 24 hours after we get your inquiry. If you are very urgent to get the quotation.Please call us or tell us in your mail, so that we could regard your inquiry priority.

We Recommend
New Arrivals
New products from manufacturers at wholesale prices